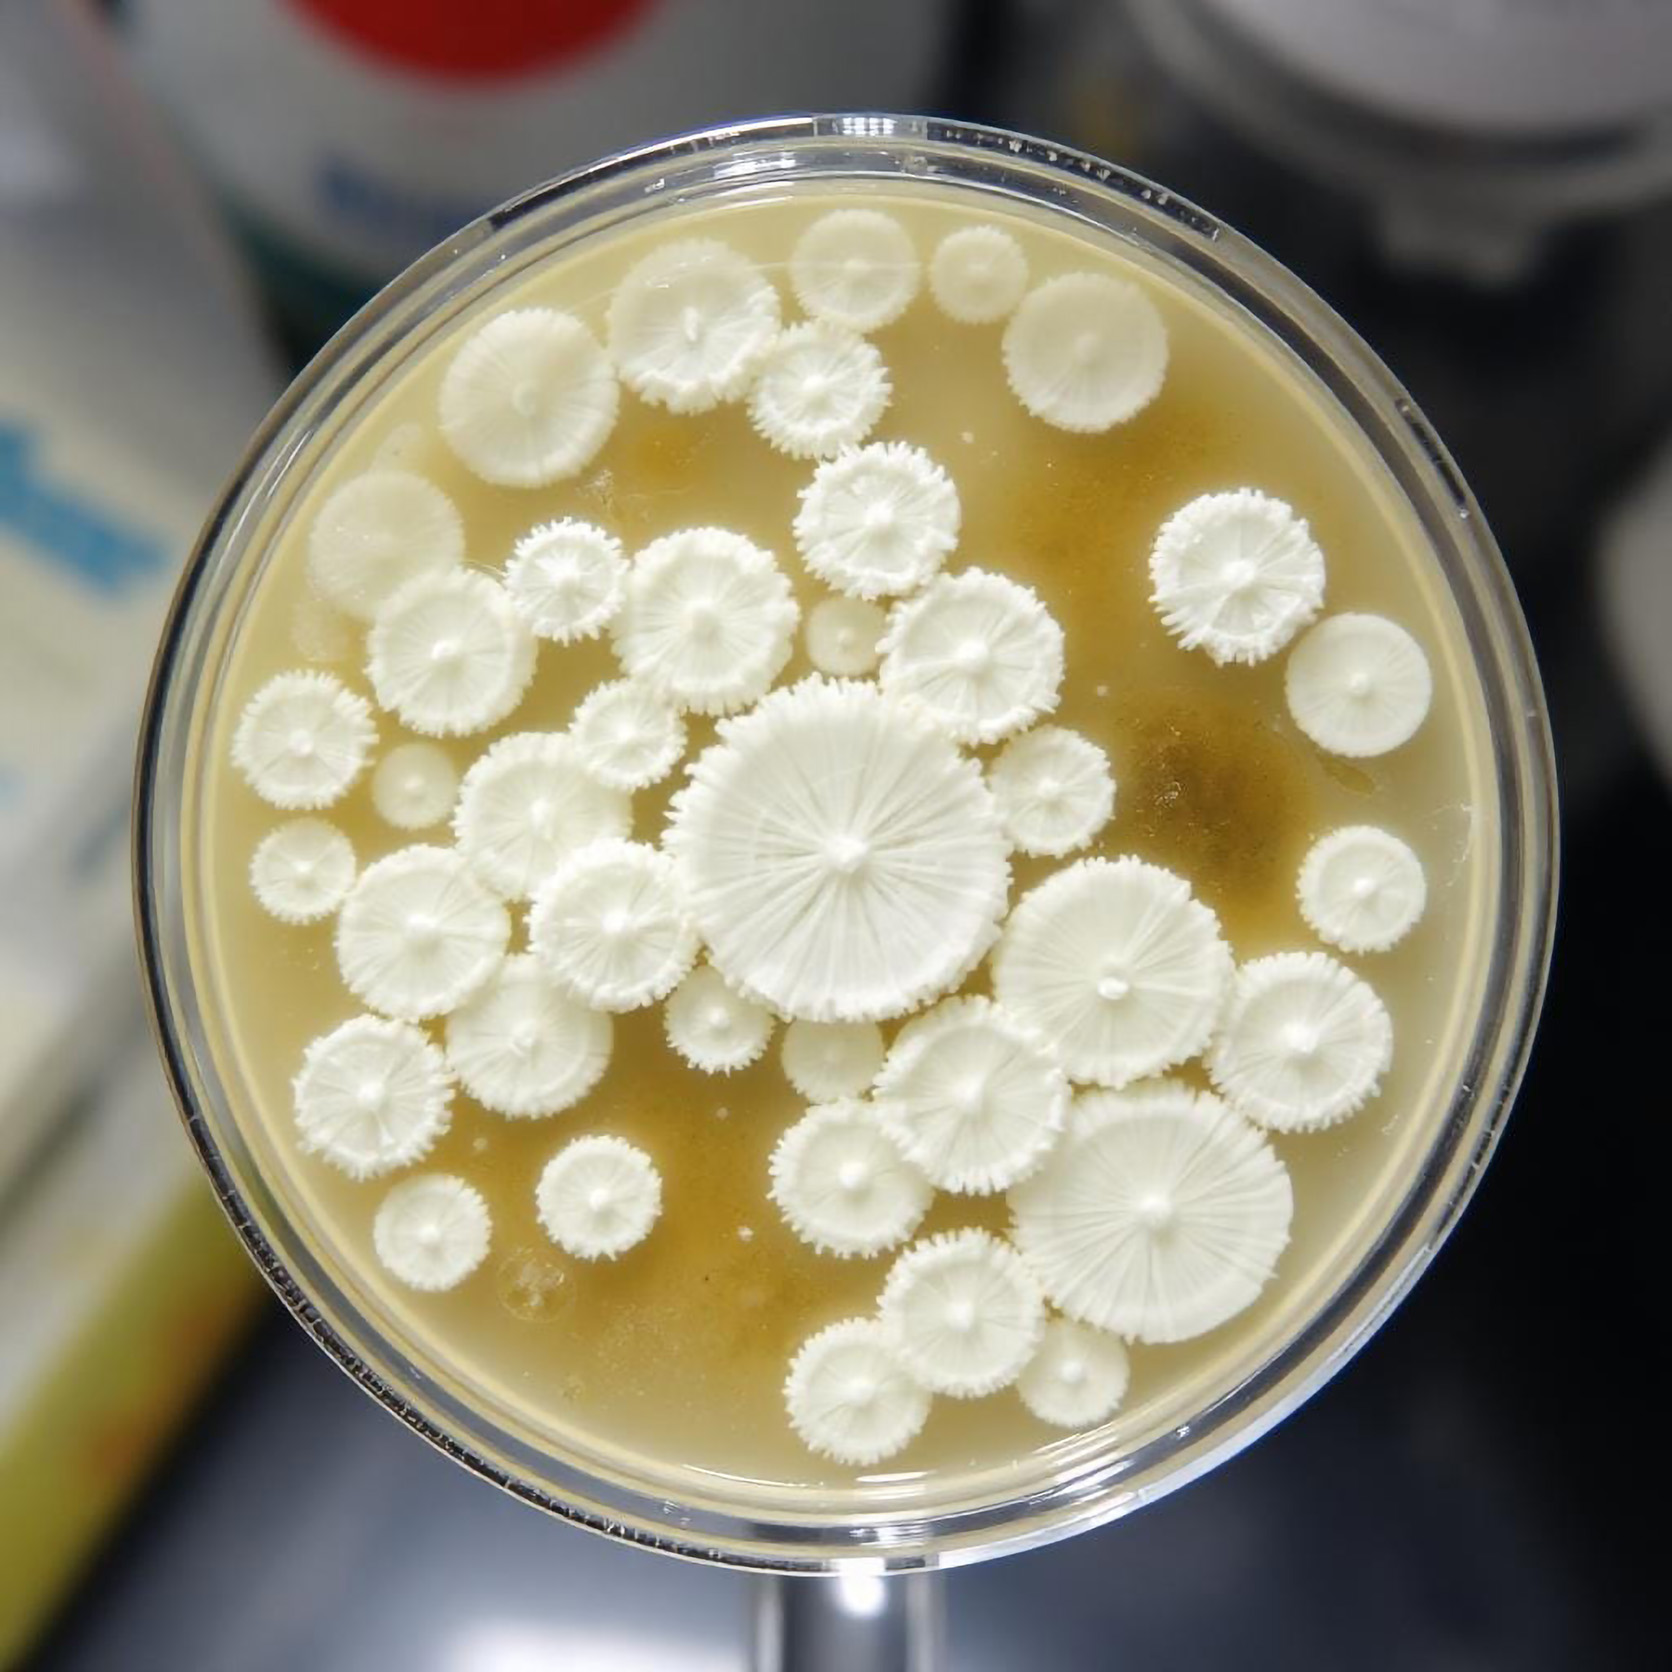
1 Coalchry-green-ourmission-home

our vision
We innovate recycling for a more sustainable future,
transforming waste into valuable resources.

our partners

Kadant – Upcycling
Engineering Efficiency Partner
Kadant – Upcycling, specialized in the production of machinery for the recycling and management of fibers and paper mill waste, supports us in engineering efficiency.

Lucart S.p.A.
Industrial Technology Partner
Italian multinational paper manufacturing company, specialized in environmentally friendly hygiene products. Lucart supports us in testing our technologies on a large scale in its plants.